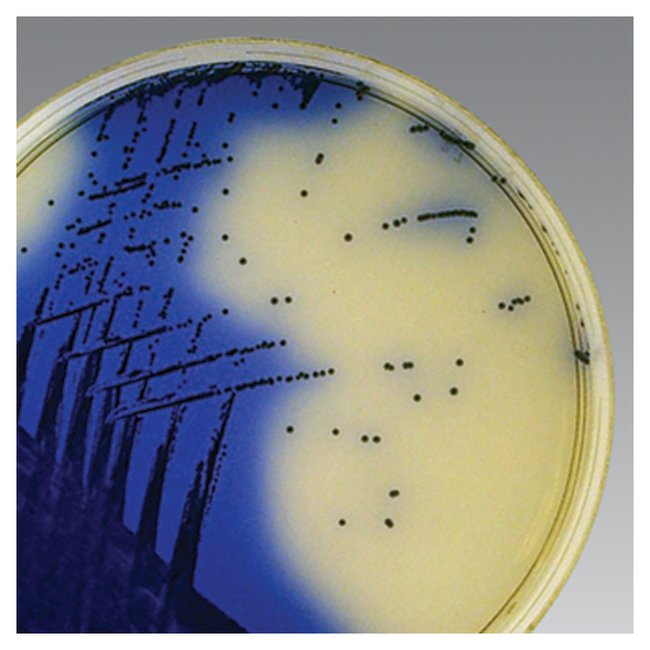

Oxoid™ Orsab Selective Supplement, Pack Of 10
$ 498.15
|
|
Details:
Oxoid orsab selective supplement (oxacillin resistance screening agar base selective supplement) is added to oxacillin resistance screening agar base, part no. Cm1008b.
Additional Information
| SKU | 1318271 |
|---|---|
| UOM | Pack of 10 |
| UNSPSC | 41115800 |
| Manufacturer Part Number | SR0195E |
